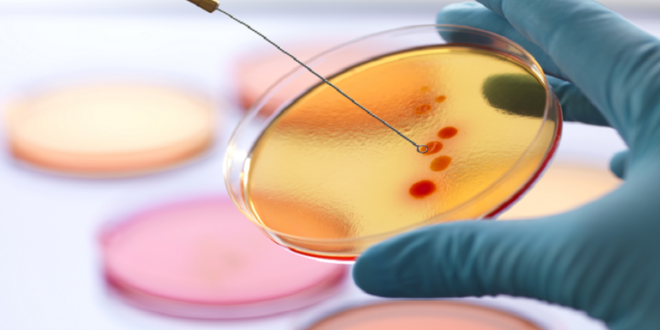

منبر العراق الحر :
اكتشف علماء جامعة إلينوي في أوربانا شامبين، مضادا حيويا جديدا، يسمى lolamicin، يمكنه التركيز على مسببات الأمراض “سلبية الغرام” دون التأثير على ميكروبات القناة الهضمية الأخرى.
تعد البكتيريا سالبة الغرام من الأسباب الشائعة للعدوى في الأمعاء والرئتين والمثانة والدم، ومن الصعب قتلها. وقال الخبراء إن مقاومتها للمضادات الحيوية الحالية تعد أحد أكثر التهديدات إلحاحا التي تواجه صحة الإنسان العالمية اليوم.
وفي التجربة، وضع العلماء lolamicin في أطباق المختبر بمواجهة 130 سلالة مقاومة للأدوية من البكتيريا الشائعة سالبة الغرام، مثل الإشريكية القولونية والمكورات الرئوية، وقتل العقار كل واحدة منها، ونجح حيث فشلت العديد من المضادات الحيوية الأخرى.
وفي القوارض الحية، نجح lolamicin أيضا في علاج الالتهاب الرئوي الحاد والتهابات الدم، مع الحفاظ على صحة ميكروبيوم الأمعاء.
ووجد العلماء أن العقار “ليس له أي تأثير على البكتيريا إيجابية الغرام أو البكتيريا المتعايشة سلبية الغرام غير المسببة للأمراض” التي كانت تعيش في الفئران.
ويعد هذا اكتشافا مثيرا لأن دورة قصيرة من استخدام المضادات الحيوية يمكن أن تسبب انخفاضا سريعا في تنوع الميكروبات التي تعيش في الأمعاء البشرية.
وأوضح فريق البحث أن العواقب الصحية لهذه التغييرات ليست مفهومة جيدا، ولكنها قد تترك المريض عرضة للعدوى الثانوية بعد استخدام بعض المضادات الحيوية.
والآن، يعمل العلماء على تحسين التجربة للتأكد من أن مسببات الأمراض لا تصبح مقاومة لـlolamicin مع مرور الوقت.
وخلصوا إلى أن “الميكروبيوم المعوي أساسي للحفاظ على صحة المضيف، ويمكن أن يؤدي اضطرابه إلى العديد من الآثار الضارة، بما في ذلك عدوى المطثية العسيرة وما بعدها”.
نشرت الدراسة في مجلة الطبيعة.
المصدر: ساينس ألرت
 منبر العراق الحر منبر العراق الحر
منبر العراق الحر منبر العراق الحر